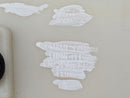
RANGE ROVER EVOQUE L538 11-15 FRONT RIGHT O/S PILLAR B UPPER TRIM BJ32-243A86-AB

Description
"King Parts" King Salvage Spare Parts KING PARTS ltd

DESCRIPTION OF PARTS:
All products are delivered within 1-2 working days
ADDITIONAL INFORMATION:
▪ The color that you see on the screen may differ to the final color of the product due to the make, model and setting of your screen.
▪ Returns are accepted, please note that returned items should be undamaged and in original packaging, buyer will
be responsible for postage costs. If item has arrived damaged or you discover any manufacturing faults please contact me as soon as possible.
WARNING! PLEASE CHECK PARCEL VERY CAREFULLY IN THE PRESENCE OF COURIER!

We recommend Our:

We accept two methods of payment: PAYPAL, and a bank transfer to our account
Payment Policy
Payment must be completed within 7 days of auction end. Non-paying bidders will be reported to eBay and begin the unpaid item process. If the item has not arrived within 14
working days after payment, please contact us.
We reserve the right to cancel the transaction and relist the item if payment has not been received within this time frame. Also we do not guarantee availability after 7 days.
Accurate shipping address and phone number MUST be included with order. Please include this information in PayPal when placing your order. Items will be shipped once the payment
has cleared.
PayPal
Paypal is our preferred method of payment (easiest and fastest way to pay for your order).
Cheques & Bank Transfers
We do accept other forms of payments such as Cheques and Direct Bank Transfer (all information and the bank details will be sent via email on request).
These forms of payments should be payable to KING PARTS ltd
Please note: We do not accept Postal Orders and credit or debit card payments over the phone.
Shipping Policy
The item order is sent after receiving full payment.
The delivery time for the item is 1-2 working days.
All items are sent via Parcelforce or Royalmail.
Orders are sent it 1 days works.
If the item did not arrive after 14 working days or the item arrived damaged or faulty please contact us via eBay message.
In very few cases if there is no ordered pattern or colour, in this case the order can be delayed by around 14 days. If this case will ever happen the customer will be
informed.
If the customer does not wish to accept the order on the terms of the shipping time being too long, the full payment will be refunded.
Returns Policy
We want your shopping experience to be a happy one and wish to avoid any complications later on.
The package content must be checked before the courier leaves. If any damage is noticed to the product it must be reported to the courier.
If the courier does not make a report I will not accept returns. The scan of the report should be sent to me via eBay message.
All items must be returned in its original packaging.
"King Parts" King Salvage Spare Parts KING PARTS ltd
Payment & Security
Your payment information is processed securely. We do not store credit card details nor have access to your credit card information.